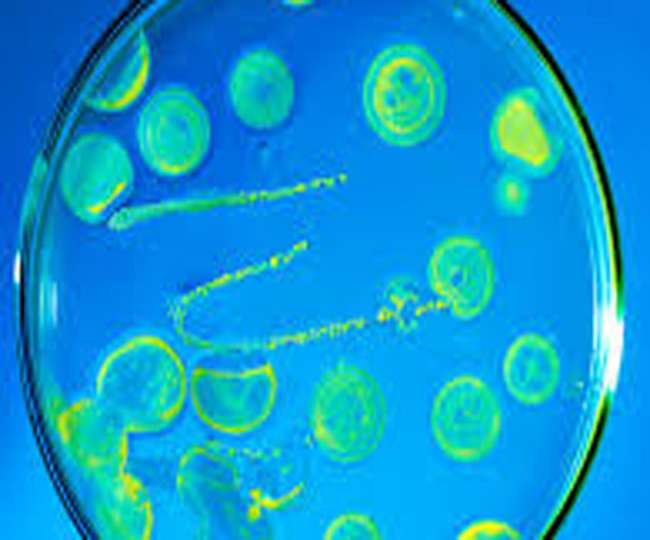
News Article Hero Image

टॉयलेट सीट से भी अधिक घातक यहां पाए जाते बैक्टीरिया, जानिए
ऐसी बहुत सी चीजें हैं जिन्हें छूने से पहले हमें बिल्कुल ध्यान नहीं आता कि इनमें घातक बैक्टीरिया भी हो सकते हैं। ...और पढ़ें
जमशेदपुर (जेएनएन)। हम रोजाना जाने-अनजाने कई ऐसी गलतियां करते हैं जो हमारी सेहत पर भारी पड़ सकती हैं। भोजन करने से पहले अगर आप हाथ धोना नहीं भूलते हैं तो यह अच्छी बात है लेकिन खाना खाते समय यदि मोबाइल भी इस्तेमाल करते हैं तो आपके हाथ धोने का कोई फायदा नहीं। आप बैक्टीरिया की जद में आ सकते हैं। ऐसी बहुत सी चीजें हैं जिन्हें छूने से पहले हमें बिल्कुल ध्यान नहीं आता कि इनमें घातक बैक्टीरिया भी हो सकते हैं।
एक सामान्य फफूंद लगी ब्रेड से ज्यादा बैक्टीरिया आपके बाथरूम में टंगे ब्रश होल्डर या वॉलेट में रखे नोट्स में हो सकते हैं। स्मार्टफोन पर टॉयलेट सीट से ज्यादा बैक्टीरिया पाए जाते हैं। जहां टॉयलेट सीट में बैक्टीरिया की तीन प्रजातियां पाई जाती हैं। वहीं, मोबाइल पर इनकी प्रजाति की संख्या 10 से 12 होती है। मोबाइल स्क्रीन पर ई-कोलाइ और फीकल जैसे खतरनाक बैक्टीरिया पाए जाते हैं। ये बैक्टीरिया हमें और आपको बीमार कर सकते हैं। इनसे बचने का तरीका यह है कि बस थोड़ा सावधान रहें। सतर्कता के साथ साफ-सफाई का ध्यान रखें। आइए आपको बताते हैं ऐसी सबसे गंदी और बैक्टीरिया से भरी चीजें जिनका इस्तेमाल आप रोजाना करते हैं मगर इसके दुष्प्रभाव से अनजान रहते हैं।
मोबाइल : मोबाइल आज के समय की सबसे बड़ी जरूरत बन कर उभरा है। ये ऐसा डिवाइस है जो ज्यादातर लोगों के साथ हर समय हर जगह मौजूद होता है। लेकिन क्या आप जानते हैं कि आपके मोबाइल पर आपकी टॉयलेट सीट से 10 गुना ज्यादा बैक्टीरिया हो सकते हैं। मोबाइल की बॉडी पर लगे बैक्टीरिया के कारण डायरिया और पेट की बीमारियां हो सकती हैं। इसलिए यदि आप मोबाइल का ज्यादा इस्तेमाल करते हैं तो आपको हर दो घंटे में हाथों को साबुन से धोना चाहिए या सैनिटाइजर का इस्तेमाल करना चाहिए।
रिमोट कंट्रोल : रिमोट कंट्रोल ऐसा डिवाइस है जिसे घर में लगभग सभी छूते हैं। छोटे बच्चे तो कभी-कभी इसे मुंह में भी भर लेते हैं। कई बार रिमोट आपके सोफा कुशन में चला जाता है या बेड पर पड़ा रहता है या जमीन में गिर जाता है और आप इसे उठाकर आराम से रख देते हैं। लेकिन क्या आपको पता है कि रिमोट कंट्रोल की बॉडी पर भी ढेर सारे वायरस और बैक्टीरिया होते हैं जो आपको बीमार बनाने के लिए काफी हैं। रोजाना रिमोट को दो-तीन बार एंटीबैक्टीरियल सॉल्यूशन से पोछें।
कंप्यूटर की-बोर्ड : आपके कंप्यूटर या लैपटॉप का की-बोर्ड भी आपको बीमार बना सकता है क्योंकि इसपर भी ढेर सारे वायरस और बैक्टीरिया मौजूद होते हैं। काम के दौरान कई बार आप की-बोर्ड के आसपास ही खा-पी लेते हैं या बच्चे गेम खेलने लगते हैं। इसके अलावा दिनभर छूने से इस पर ढेर सारे जम्र्स जमा हो जाते हैं। इसके लिए आपको की-बोर्ड को काम से पहले एल्कोहल सॉल्युशन से साफ करना चाहिए।
बर्तन धोने का स्पॉन्ज या स्क्रबर : घर में मौजूद जिन चीजों में सबसे ज्यादा जम्र्स और बैक्टीरिया हो सकते हैं उनमें से एक बर्तन धोने का स्पॉन्ज या स्क्रबर भी है। इसका कारण ये है कि कई बार ये धूल और कच्चे-पके भोजन के सीधे संपर्क में आता है और ज्यादातर समय गीला रहता है, इसलिए यह आपकी सेहत के लिए खतरनाक हो सकता है।
टूथब्रश होल्डर : दांतों को बीमारी से बचाने के लिए आप टूथब्रश का इस्तेमाल करते हैं। ब्रश करने के बाद जब आप इसे धोते हैं तो इसके ब्रिसल्स पर लगे जम्र्स कम पानी के साथ बह जाते हैं मगर फिर भी इतने जम्र्स आपके टूथब्रश में रह जाते हैं जो आपको बीमार बनाने के लिए काफी हैं। आपके वॉशरूम में मौजूद चीजों में सबसे ज्यादा जम्र्स इसी ब्रश होल्डर या ब्रश पर होते हैं।
रुपये- पैसे : रुपया-पैसा ऐसी चीज है जो सबसे ज्यादा हाथों द्वारा इस्तेमाल की जाती है। इतने सारे हाथों और जगहों से गुजरते हुए इसमें ढेर सारे हानिकारक बैक्टीरिया चिपक जाते हैं। इसके अलावा कुछ लोग नोट गिनने के लिए थूक का इस्तेमाल करते हैं, जिससे ढेर सारे वायरस उनके मुंह के रास्ते उनके पेट तक पहुंच जाते हैं। एक शोध के मुताबिक एक नोट में लगभग 3000 अलग-अलग तरह के वायरस मौजूद होते हैं। नोट को छूने से आपके हाथों में ये वायरस और बैक्टीरिया आ जाते हैं और फिर आपको बीमार बनाते हैं।
वॉयलेट और पर्स : पर्स या वॉयलेट का इस्तेमाल ज्यादातर लोग घर से बाहर रहने पर करते हैं। दिनभर इसे छूते रहने से और पैसा सिक्का आदि को इसमें रखने से इसमें भी ढेर सारे वायरस और बैक्टीरिया आ जाते हैं। इसके अलावा कई बार पर्स को आप दुकानों के काउंटर में, बाथरूम के स्टॉल्स पर या कार की सीट पर रख देते हैं जिससे ये बेहद गंदे हो जाते हैं।
एटीएम मशीन : एटीएम का इस्तेमाल दिन भर अलग-अलग लोग करते हैं। सबके हाथों से होते हुए हजारों तरह के वायरस और बैक्टीरिया इस एटीएम मशीन की बॉडी और की-पैड पर मौजूद होते हैं। लेकिन एटीएम का इस्तेमाल करते समय आपको कभी इस बात का ध्यान नहीं आया होगा।
वॉशरूम हैंडल : वॉशरूम में जब आप सोप डिस्पेंसर से लिक्विड सोप निकालकर हाथ धोते हैं तो सोचते हैं कि हाथ अब पूरी तरह साफ है। लेकिन बाहर निकलने के लिए जैसे ही आप वॉशरूम के दरवाजे का हैंडल पकड़ते हैं, वैसे ही ढेर सारे वायरस और बैक्टीरिया फिर से आपके हाथों में लग जाते हैं।
किचन टॉवल : किचन में काम करते हुए गीले बर्तनों और हाथों को पोंछने के लिए आप जिस किचन टॉवल का इस्तेमाल करते हैं उसमें भी ढेर सारे बैक्टीरिया और जम्र्स मौजूद हो सकते हैं। इसके लिए आप रोजाना अपने किचन टॉवल को धुलें और अच्छी तरह सुखाने के बाद ही दोबारा इस्तेमाल करें।
यह भी जानें
-10 गुना ज्यादा बैक्टीरिया हो सकते हैं मोबाइल पर आपकी टॉयलेट सीट से
- 03 प्रकार की बैक्टीरिया की प्रजातियां पाई जाती हैं टॉयलेट सीट पर
- 3000 अलग-अलग तरह के वायरस मौजूद होते हैं हमारे रुपयों में
ऐसे रहें सतर्क
- रोज रिमोट को दो-तीन बार एंटीबैक्टीरियल सॉल्यूशन से जरूर साफ करें
- की-बोर्ड को काम से पहले एल्कोहल सॉल्युशन से साफ करना चाहिए

कमेंट्स
सभी कमेंट्स (0)
बातचीत में शामिल हों
कृपया धैर्य रखें।